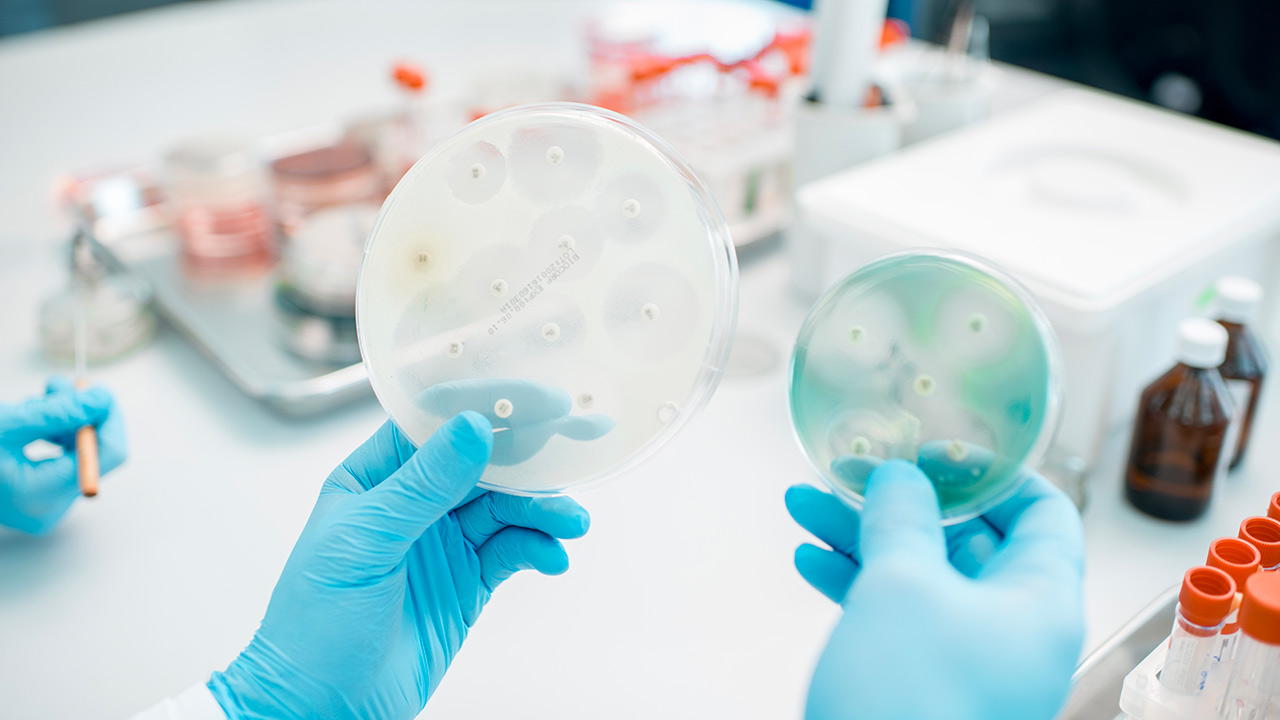
Università dell’Insubria

Università dell’Insubria. Scoperto un nuovo antibiotico contro i superbatteri
Un gruppo di ricerca internazionale coordinato dall’Università degli Studi dell’Insubria, guidato dalla professoressa Flavia Marinelli del Dipartimento di Biotecnologie e scienze della vita, ha scoperto un nuovo antibiotico glicopeptidico.
La molecola, chiamata dal team kineomicina, si è dimostrata promettente per la sua capacità di inibire la crescita di batteri patogeni attualmente resistenti alle terapie antibiotiche comunemente utilizzate.
“L’antibiotico-resistenza è quel fenomeno che si verifica quando i farmaci utilizzati per contrastare i batteri, ovvero gli antibiotici, smettono di essere efficaci. È riconosciuta dall’Organizzazione Mondiale della Sanità come una pandemia silenziosa che oggi minaccia la salute globale, rischiando di compromettere decenni di progressi in campo medico: dal trattamento di una semplice infezione all’impossibilità di effettuare interventi chirurgici complessi. Più di 35mila persone muoiono ogni anno in Europa a causa dell’antibiotico-resistenza. È pertanto urgente scoprire nuovi antibiotici, utilizzando tutti gli approcci possibili che la comunità scientifica ha a disposizione”, è quanto ha spiegato Flavia Marinelli.
Il lavoro ha mostrato come, grazie a un approccio in silico – basato sull’analisi bioinformatica di grandi quantità di dati sulla diversità microbica – sia stato possibile predire la struttura chimica di un nuovo antibiotico prodotto da un microrganismo esotico dal nome particolare: Actinokineospora auranticolor.
“La strada verso un possibile sviluppo della kineomicina come nuovo farmaco è appena iniziata – si legge in un comunicato – e richiederà numerosi ulteriori studi, sia in vitro sia in vivo. Tuttavia, questa scoperta conferma che, grazie a nuovi approcci multidisciplinari, è possibile trovare nelle risorse naturali – in questo caso nella straordinaria diversità metabolica dei microrganismi – nuove soluzioni per affrontare le infezioni multiresistenti”.









